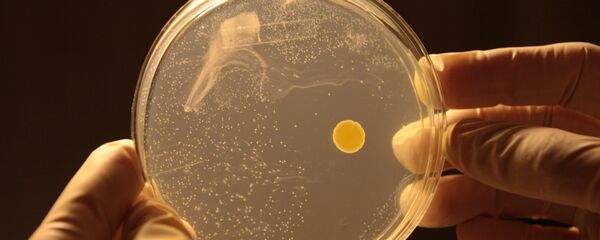
Once a spaceship is in orbit, astronauts sample the air and surfaces to check for microbes; despite passing through the atmosphere, some still remain. - Sputnik International

This time around, concerns have ignited over the mishandling of the bacteria that causes plague, a disease that killed millions of people in Europe in the 14th century and still has a fatality rate of about 93% if human infections go untreated.
"The Army investigation is under way," Defense Department spokesperson Peter Cook told reporters on Thursday. "We expect this program to be fixed."
According a senior Defense Department official, the suspect samples of plague were tested and shows to not contain the fully virulent form of plague bacteria, but a weakened version. After extensive analysis, no danger to the public or specimen researchers has been found so far, with final test results expected at the end of the month.
Cook said the Army was "working collaboratively with the CDC" on the investigation into the potential mishandling of the bacteria.
Regardless of the results of those tests, the sloppy safety practices at US military labs that the scandal has exposed have raised concerns about the handling of other lethal agents studied there, like specimens of Venezuelan equine encephalitis virus and Eastern equine encephalitis virus, which are also classified as bioterror pathogens and can cause serious illnesses, including deadly inflammation of the brain.
In response to the revelations of potential protocol lapses, an emergency ban was imposed on research of all bioterror pathogens at nine Pentagon labs. All labs will undergo safety reviews to ensure they are properly handling select agent pathogens.
According to the CDC, most of the specimen transfers went to other Defense Department facilities, and the agency is still investigating whether the shipped materials contained live pathogens and whether they pose any risk to public health.